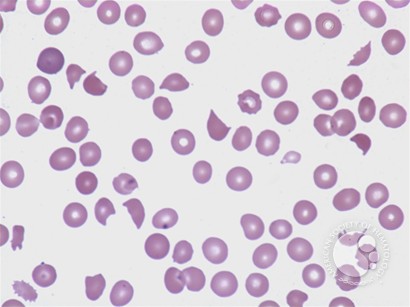
test nrbc 0 blood at room in agglutinin disease clotting cold Blood temperature test nrbc 0 blood at room in agglutinin disease clotting cold Blood temperature

34 NRBC BLOOD TEST 0
NRBC BLOOD TEST 0
Hi, many thanks for visiting this website to search for nrbc blood test 0. I really hope the info that appears may be beneficial to you

METC HEMO 101 TEST#1 Flashcards Quizlet , Hematology Tests Medical Laboratory Science 4128 with , Nucleated red blood cell count in term and preterm , Clin Path WBC Morphology Flashcards Quizlet , White blood cell test 2 Flashcards Quizlet , Nucleated red blood cells as predictors of mortality in , BCC Hematology Study for Test 01 flashcards Quizlet , Blood clotting at room temperature in cold agglutinin disease , Allied Hospital Supply International Corporation » SD ,
Hi, many thanks for visiting this website to search for nrbc blood test 0. I really hope the info that appears may be beneficial to you






Belum ada Komentar untuk "34 NRBC BLOOD TEST 0"
Posting Komentar